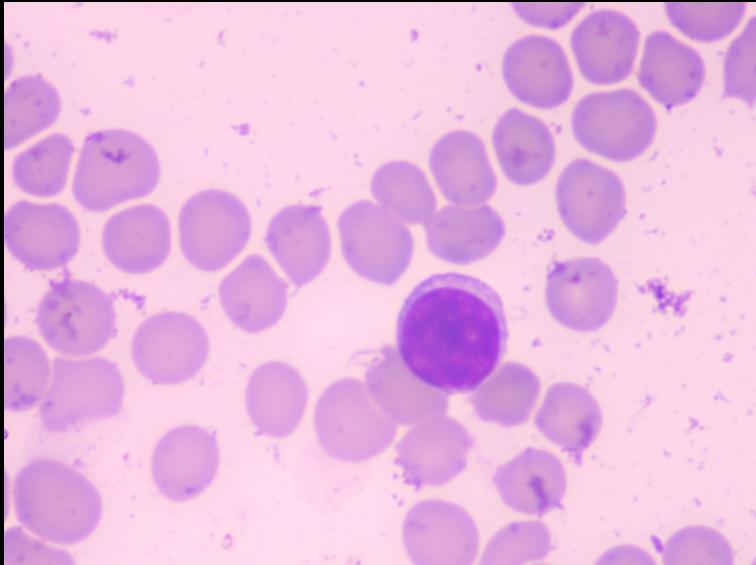
猫咪爪垫红肿怎么办,猫咪的爪垫会蜕皮吗
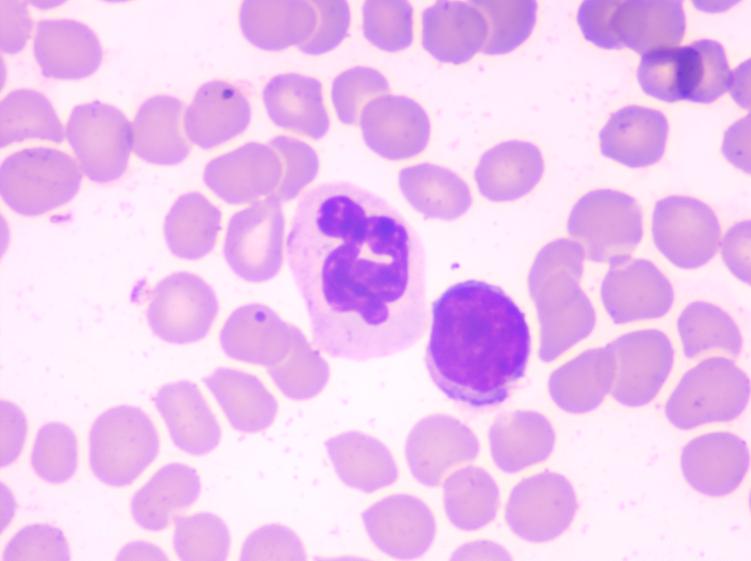
猫咪爪垫红肿怎么办,猫咪的爪垫会蜕皮吗

猫咪全身上下,都能够让人感觉可爱、萌到飞起, 但其中超级软糯的莫过于小肉垫!
超像一团棉花糖,按一按就会扁扁的。

白白的一团,就像山竹一样,没有哪个铲屎官不想吸上一口。

但随着天气变冷,小伙伴反应:
——猫咪的爪垫开始干燥、起皮、甚至出现了裂口?
——也有家长会发现猫咪频繁舔舐爪部。
这究竟是怎么回事呢?
⚠️宠小爱不得不提醒大家,要注意猫咪可能正遭受疾病的痛苦。 今天就为家长们介绍一则 宠爱国际 的猫科、老年病科专家 「刘思屯」 院长接诊的 「猫淋巴浆细胞性爪部皮炎」 病例,一起来了解下:

〖 宠 爱 国 际 病 历 本 〗

- 宠物名:点点
- 性别:男孩
- 年龄:未知
- 品种:田园猫
- 体重:3kg
主诉病史
今年年初时发现该猫爪垫有发炎的情况,
当时自行外用过抗生素药膏,
最近去喂食发现情况情况进一步恶化,
地上都是血迹,并且伴随跛行。
于是带到医院进行治疗。
医院检查
临床检查:
来院检查时,猫咪鼻湿,精神紧张,腹部软,CRI<2S,BCS4/9,双侧前肢肉垫严重肿胀, 破溃,可见脓性分泌物与血迹。 清创后也可见严重肿胀破溃脚垫。
01

02

03

实验室检查:
血常规检查

细胞学检查
可见淋巴细胞
可见中性粒细胞与淋巴细胞

可见大量中性粒细胞与浆细胞

细胞学:可见大量浆细胞,
少量淋巴细胞和中性粒细胞。
皮肤组织病理学:
浆细胞和桑葚状细胞。
初步诊断
「猫淋巴浆细胞性爪部皮炎」
猫咪症状符合猫浆细胞爪部皮炎特点:
前肢脚垫均肿胀,
变软,海绵状甚至破溃。
治疗方案
住院期间,为猫咪每日进行清创,
控制出现继发感染的情况。
同时用药物缓解,止痛恢复。
住院治疗两周后患处明显恢复。

01

02

03

住院两周后出院,回家两周后复建,猫咪状态恢复正常,基本无异常 ,爪部基本愈合, 吃喝正常,大小便正常,精神状态良好。

如今猫咪已经恢复健康,精神状态、食欲都非常好, 像往常一样可以活蹦乱跳 。


病例讨论
淋巴浆细胞性爪部皮炎
淋巴浆细胞性爪部皮炎也称为猫浆细胞性爪部皮炎或糊状爪部疾病。是一种目前研究还不清楚的疾病。主要影响腕、掌骨、足垫。 罕见情况下同样的病例过程也可影响到鼻甲骨 。患病猫咪的足垫松软呈糊状, 表面可皱缩极易剥落。
在更为严重的病例,足垫可发生溃疡、出血表现疼痛。有些猫只是一个足垫发病, 而有些猫咪则是所有足垫均发病。 猫咪常常因跛行或者出血而就医。偶尔可在鼻的背部出血弥散性肿胀, 同时伴有足垫损伤。
关于本病的病因还不清楚,但是在一项研究中发现患病猫50%感染有猫免疫缺陷病毒。本病主要的鉴别诊断包括胞疮和类毛体线虫侵染。 如果只有鼻梁骨发病,则鉴别诊断包括感染性因素,如隐球菌及其他真菌和不常见细菌引起的感染 。需要注意的是虽然本病在后期的治疗中痊愈了,但还是有可能会复发。

宠爱国际再生医学科
(干细胞治疗、PRP康复治疗)
该科室旨在进一步加强造血干细胞再生基础研究新技术成果的临床转化应用,如富血小板血浆(PRP)康复治疗,自体PRP是 患宠 血液的一小部分,使损伤组织生物再生而非对其进行替换,围绕造血再生创新性技术, 如造血干细胞动员扩增、细胞免疫治疗、单基因遗传血液病基因修饰治疗,重点开展造血功能低下、自身免疫性疾病的创新性临床研究。
宠爱国际猫科
该科室得益于医院专业的猫病诊断及照护能力,包括猫的慢性口炎及慢性肾衰竭、异物手术、血球血液及气体分析、预防医学及老年猫医学等,给爱猫提供完善的医疗照顾, 致力于猫科医疗质量与福利,并针对猫咪特质来教育猫咪家长对于看诊流程的配合,让猫咪能快乐上医院并将紧迫性降至更低。
预防方案及康复后保健措施
医生,日常如何保护猫咪的爪部呢?
猫咪的肉垫上分布了很多敏感的神经 ,它们的肉垫表面皮肤比其它长毛部位皮肤更厚实一些,肉垫皮肤内侧分布了很多的神经,这些神经可以敏锐的感知外界,不仅能帮助它们评估猎物的距离和活跃度,还能让它们保持身体的平衡。
日常生活中可用毛巾或棉球蘸温水擦拭、 湿敷猫咪肉垫,软化角质层。也可轻轻涂抹护足霜充分按摩吸收一会儿。
注意护足霜别让猫咪舔个没完, 否则不仅会让猫咪全都吃进去,如果有小伤口,还可能会让肉垫变得更糟糕。
都有哪些情况能够会使得猫咪爪部干燥开裂呢?
正常状态下, 猫咪的小肉垫应该是饱满、有弹性且光滑柔软的。 那么为什么会皲裂呢?
①缺少水分摄入。
当猫咪饮水量不足,身体缺水,便会导致出现干裂的情况。
②身体缺乏营养。
猫咪身体缺乏营养时候,皮肤、爪部也会受损,如缺锌。
③温度过冷或过热。
温度差过大,会让猫咪爪垫受损,尤其是出门行走的猫咪,爪部很容易损伤。
如果猫咪肉垫,尤其是靠近趾间的位置角质增厚、肿胀,严重开裂甚至流血,这时候家长们需要注意! 也有可能是因为疾病因素的影响,如:
❗️真菌、细菌引发的皮肤炎。
❗️蚊虫叮咬造成的过敏。
❗️外伤导致的进一步感染。
❗️户外或家里的化学剂伤害。
❗️免疫系统或内分泌疾病。
❗️癌症。
此时家长应特别注意,并带毛孩到医院进行检查。
好的,谢谢医生。
主治医师
